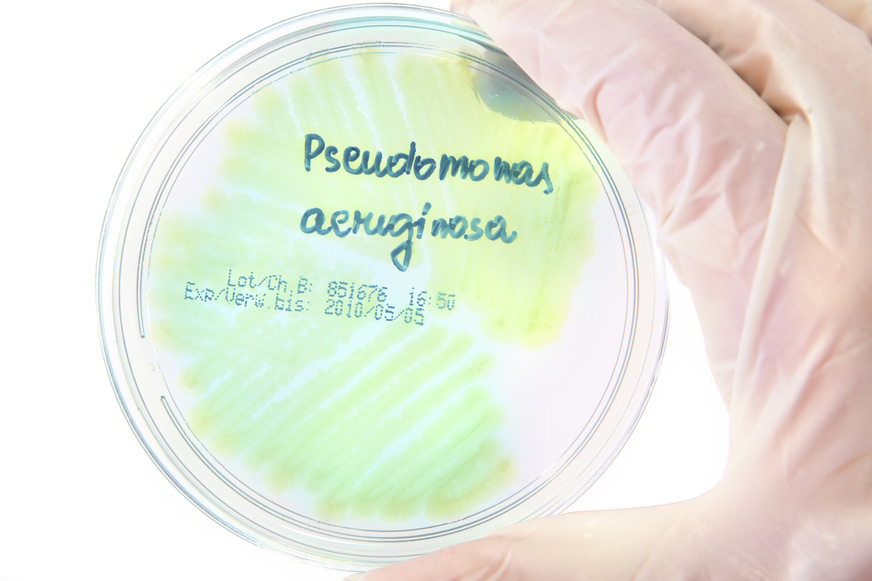
Das Bakterium Pseudomonas aeruginosa (PSA) in einer Petrischale

Der Pumpen- und Pumpensystemlösungsanbieter Wilo etabliert die thermische Desinfektion von Trinkwasser-Druckerhöhungsanlagen fest in Produktionsprozess und Produktportfolio – und setzt damit neue Hygiene-Maßstäbe. Wilo-ThermoDes umfasst die Reinigung von Wilo-Druckerhöhungsanlagen mithilfe dieses anerkannten Desinfektionsverfahrens sowohl ab Werk als auch am Einbauort.
Thermische Desinfektion als Zusatz zur chemischen Reinigung
Zwar werden Wilo-Druckerhöhungsanlagen längst nach allgemein anerkannten Regeln der Technik im Werk chemisch desinfiziert. „Wir gehen ab jetzt aber noch einen entscheidenden Schritt weiter“, sagt Dirk Böttcher, Wilo-Produktportfoliomanager Wasserversorgung. Meint: Die Wilo-Druckerhöhungsanlagen für Deutschland, Österreich und die Schweiz werden im Werk in Oschersleben (Sachsen-Anhalt) nicht nur chemisch, sondern auch thermisch desinfiziert, bevor sie mit verschlossenen Rohrenden und in einer Schutzverpackung ausgeliefert werden.
Hintergründe
Gerade bei werksseitig nass geprüften Produkten für die Trinkwasserinstallation, zum Beispiel Druckerhöhungsanlagen, stellen feuchtigkeitsliebende und gesundheitsgefährdende Bakterien für alle Hersteller eine Herausforderung dar. Für das Bakterium Pseudomonas aeruginosa (PSA) etwa legt die Trinkwasserverordnung einen strengen Grenzwert von 0 KBE je 100 ml fest. „Mit der thermischen Desinfektion als Zusatz zum chemischen Desinfektionsverfahren implementieren wir ein anerkanntes Verfahren, um diesen Krankheitserreger effizient zu eliminieren und schaffen so ein echtes Hygiene-Plus. Mit diesem Prozess und der daraus resultierenden Wilo-Herstellererklärung geben wir unseren Kunden die Sicherheit, ein Produkt im Sinne der mikrobiologischen Anforderungen der Trinkwasserverordnung erworben zu haben“, sagt Dirk Böttcher. „Wir können eben diese hygienische Sicherheit bis zur Auslieferung ab Werk garantieren. Allerdings können wir nicht völlig ausschließen, dass die Anlagen bei Folgeprozessen, die nicht unserer Einflussnahme unterliegen – zum Beispiel beim Transport, bei der Lagerung, der Installation oder auch bei langen Standzeiten unter Wasser – möglicherweise noch verunreinigt werden.“ Doch auch darauf habe Wilo eine Antwort, so Böttcher: Wilo-ThermoDes mobil.
Desinfektion vor Ort
„Die thermische Desinfektion direkt am Einbauort schafft noch mehr Sicherheit für Fachhandwerker, Betreiber und Endgebraucher“, sagt Rainer Rixen, Wilo-Serviceleiter. Der Wilo-Werkskundendienst, der allein deutschlandweit mit über 70 Technikern im Einsatz ist, desinfiziert die Druckerhöhungsanlage dabei mithilfe der mobilen Wilo-ThermoDes-Box direkt vor dem ersten Einbau oder im wieder ausgebauten Zustand. „Für Wilo-ThermoDes mobil gilt wie für die Reinigung ab Werk: Auf die Zuverlässigkeit der thermischen Desinfektion können sich unsere Kunden verlassen“, sagt Rainer Rixen.
Bestätigt durch Prüfinstitut
Im thermischen Desinfektionsprozess werden alle medienberührenden Oberflächen für mehrere Minuten auf über 70° C erhitzt. Die Hitze durchdringt Biofilme besser und tötet diese erfolgreicher ab als Chemikalien. Zudem werden bei der thermischen Desinfektion aktive und inaktive PSA-Bakterienstadien vollständig eliminiert. „Dieses Verfahren ist durch das unabhängige Institut IWW, das Rheinisch-Westfälische Institut für Wasser, bestätigt und zertifiziert“, so Böttcher weiter.
„Wir sind überzeugt: Mit Wilo-ThermoDes haben wir ein auf dem Markt einzigartiges, sicheres und flexibles Angebot geschaffen. Unsere Kunden kaufen hygienisch einwandfreie Anlagen“, sagt Rainer Rixen. Wer allerdings alle hygienischen Risiken bis zum Übergang in den bestimmungsgemäßen Betrieb der Druckerhöhungsanlage ausschließen wolle, komme einfach auf Wilo-ThermoDes mobil zurück. „Und das ab sofort – das Angebot gilt bereits!“, so Rixen.
Bild: Getty Images/ihumonia